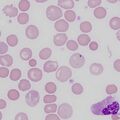
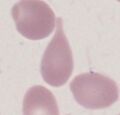
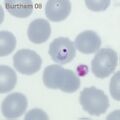
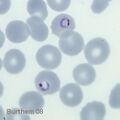
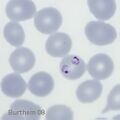
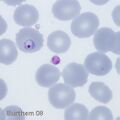
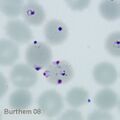

Unused files
The following files exist but are not embedded in any page. Please note that other web sites may link to a file with a direct URL, and so may still be listed here despite being in active use.
Showing below up to 50 results in range #1 to #50.
- Getting fixed.jpg 756 × 720; 94 KB
- BS1.png 472 × 472; 96 KB
- BS5.jpg 472 × 472; 33 KB
- Kt1.png 472 × 472; 76 KB
- HG1.png 472 × 472; 58 KB
- Boat1.png 472 × 472; 60 KB
- Ec6.jpg 472 × 472; 45 KB
- TC1.png 472 × 472; 63 KB
- TD1.png 472 × 472; 73 KB
- TD2.jpg 492 × 472; 46 KB
- DM2.jpg 472 × 472; 43 KB
- SC1.png 472 × 472; 126 KB
- Ellip1.png 472 × 472; 75 KB
- Ellip4.JPG 472 × 472; 58 KB
- Crys1.png 472 × 472; 63 KB
- Crys2.jpg 472 × 472; 27 KB
- HJ1.png 472 × 472; 87 KB
- HJ2.jpg 472 × 472; 32 KB
- IRC1.png 472 × 472; 71 KB
- IRC2.jpg 472 × 472; 30 KB
- Nrbc1.png 393 × 393; 103 KB
- Ova1.png 472 × 472; 83 KB
- PH2.jpg 472 × 472; 27 KB
- Pen1.png 374 × 380; 91 KB
- SP1.png 472 × 472; 125 KB
- SP2.jpg 472 × 472; 43 KB
- St0.png 472 × 472; 57 KB
- Mac0.png 472 × 472; 145 KB
- HypoC0.png 596 × 639; 166 KB
- AnisoC0.png 472 × 472; 124 KB
- Aniso0.png 472 × 472; 135 KB
- Nrbc0.png 472 × 472; 105 KB
- PolyC0.png 472 × 472; 91 KB
- NRBC1B.png 474 × 471; 106 KB
- MSp0.jpg 472 × 472; 39 KB
- TC1A.png 472 × 472; 87 KB
- IRC2B.png 472 × 472; 109 KB
- BS0.png 472 × 472; 88 KB
- CLLCD45.jpg 394 × 270; 83 KB
- CD45 populations.png 1,119 × 1,074; 427 KB
- CD45-PopB.png 591 × 472; 233 KB
- FVETc.jpg 472 × 472; 67 KB
- PFETi1.jpg 295 × 295; 35 KB
- PFETi2.jpg 295 × 295; 35 KB
- PFETi3.jpg 295 × 295; 36 KB
- PFETi4.jpg 295 × 295; 36 KB
- PFETi5.jpg 295 × 295; 37 KB
- PFETi6.jpg 295 × 295; 38 KB
- MMLTr2.jpg 342 × 342; 25 KB
- 11double3.jpg 472 × 472; 28 KB